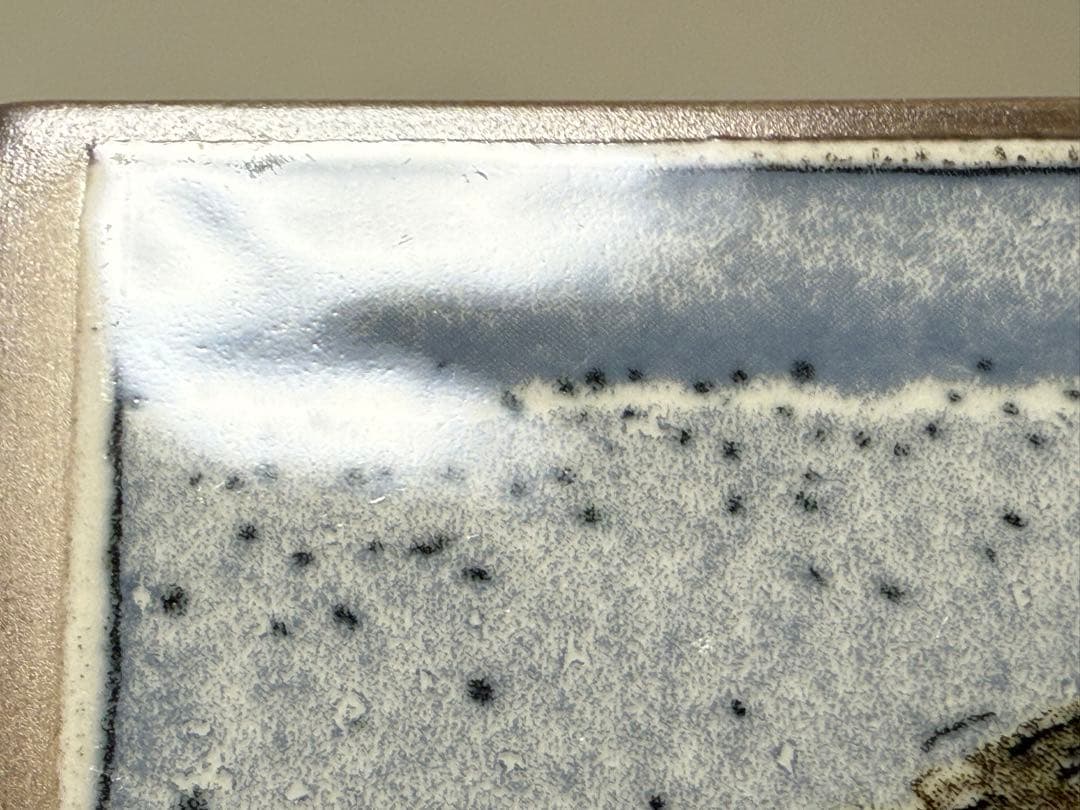
ウサギの巣 1983年 アラビア ヘルヤ 陶板画 Arabia

ウサギの巣 1983年 アラビア ヘルヤ 陶板画 Arabia
(2719件)
Pontaパス特典
サンキュー配送
6496円(税込)
65ポイント(1%)
Pontaパス会員ならさらに+1%ポイント還元!
送料
(
)
2702
配送情報
お届け予定日:2026.05.01 3:27までにお届け
※一部地域・離島につきましては、表示のお届け予定日期間内にお届けできない場合があります。
ロットナンバー
33183289383
お買い物の前にチェック!

Pontaパス会員なら
ポイント+1%
ポイント+1%
商品説明
ウサギの絵本で世界的に有名なヘルヤの陶板画です。ウサギの子どもたちが巣に密集している様子が可愛らしい作品です。メーカー:アラビア作家:ヘルヤ・リウッコ・スンドストロム作品名:Rabbit Nest(ウサギの巣:直訳)年代:1983年サイズ:約11.5cm x 11.5cmオリジナルボックス:なし状態:ビンテージです。表面にはスレキズが複数あります。(画像3〜16)裏面には汚れや紙フックからはみ出した接着剤のあとがあります。(画像17) (画像ははっきり見えるように撮影しています。) 陶磁製品は素地や釉薬の特性上、形状・質感に多少の違いが出たり、表面に小さな黒点や釉薬上のへこみ(ピンホール)が生じることがあります。 ビンテージ製品および陶磁製品の性質をご理解した上でご購入ください。また、感じ方には個人差がありますので、少しでも不明な点があれば事前にご質問をお願いします。 梱包はリサイクル資材を使用します。 即購入OKです。#イッタラ # #ヌータヤルヴィ #Nuutajarvi #アラビア #ARABIA #スコープ #scope #北欧 #ビンテージ #ヴィンテージ #Vintage #アンティーク #Antique #ヘルヤ #Helja。4.2kg特大水晶・虹入・オーラフレーム・ヒマラヤ スカルドゥ産カテドラル水晶。ナタリー・レテ アフタヌーンティー 張り子 招きねこ 招き猫。高野夕輝 木彫り熊 オブジェ 903会 熊。Kieku 2006年 箱付き ニワトリ イッタラ バード オイバ・トイッカ。天使の石 ペタライト 原石 オールドストック。マイセンクリスタル。939 九谷焼 玉乗り獅子 魔除け 置物 時代物。スワロフスキー スターウォーズR2D2 希少品。特別出品 欧州中世象嵌タイル 古道具 アンティーク ビンテージ 骨董 古美術。【希少品】木彫りのおきもの リングマ&コイキング ポケモンセンター。ミッキーマウス 加藤工芸レビュー
商品の評価:




 4.6点(2719件)
4.6点(2719件)
- tetsu19752014
- クリスタルかガラスのあまり大きくない、龍の置物を探していて、こちらの龍を見つけて、購入しました。 赤い箱に入っていて 龍がとてもきれいでした。 買ってよかったです。
- くまもんマミー
- おしゃれなガラス雛飾りです! 初節句のお祝いにプレゼントしたのですが 大きさ、手作り感そしてガラスの透明感の美しさ 喜ばれました! 作家の立札などが付いてたら 格が上がるなと思います(^^)
- ピィちゃん89
- ガラスドームのアクセントに。 カタツムリみたいでかわいいですね。 白っぽい貝が多いので、狙い通りのアクセントになってくれています。
- おやっっっさん。
- ちょっと早いけどすぐに届けて頂いたので早速、渡しました〜。とても喜んでくれましたよ。 前から気になっていたので私も嬉しいですっ インテリアにもなるしお天気予報もできるし 何より喜んでくれたのでこちらで買って良かったです
- 15年ぶりの取替
- 手帳型カバーを使っているのでなかなか置くのが難しいけれど可愛いので使っています 手帳型でも置ける物があれば嬉しいです
- 遊貴1134
- 一目惚れで買いました。 バイオリンのうさぎも捨て難く、一緒に買って正解でした。 並べて置くととっても可愛いです。 サイズも丁度良かったです。 191513-20210323-00122739
- lain66
- 以前は武者のぼりに家紋や名前を入れたりしていましたが昭和的な物はやめて邪魔にならず小さくても思いが込められるこちらの5月飾りにしました、大きな物だと使わなくなった時に処分に困るのでこれからの時代にぴったりな贈り物ですね。発送も早く対応も親切で、素敵に仕上がっていました、ありがとうございました。
- Longaho
- カエル好きの子が、辞めるので送別品をと思い探していたらこちらの商品にたどり着く。戦隊シリーズが好きワケではないが、少しのウケ狙いを兼ねて他の色も購入。喜んで貰えたので、良かった。
- asawan2
- 2つ並べると、更に可愛いです。 迅速な対応に、感謝致します。m(__)m
- 楽天0125
- お値段が安いので安っぽかったらイヤだと思ってましたが杞憂でした!このお値段に見えません。額付きですし、大満足です!
- たべ0846
- プレゼント用に購入しました。 とても喜んでもらえて私も嬉しかったです。 送ってくれた写真を見ましたが、すごく可愛かったです。 また、配送も早くプレゼントのラッピングはお願い出来ませんでしたが、とてもきれいに梱包されていたそうで全てにおいて満足なお買い物ができました。 今度は自分用に購入しようと思います。
- ばーむーです
- 本当は羽をひろげている鳥にしたかったのですが、飾る場所が狭めなのでカケスにしました。 でもとても素敵で、不安定に動くのに絶対落ちないところがすごいです。 注文時、いったんハヤブサの金額で表示されますが、後できちんと修正されます。
- moe222
- 知り合いが 愛犬を亡くし 愛犬の供養に蓮乗りのお地蔵様と足型のお香立てが欲しいと言っていたので 愛犬の供養と共に 知り合いの今後を 愛犬の様に お地蔵様に見守って貰えたらと 私自身がお願いしたいと思ったので お願いお地蔵様と足型のお香立てを ご用意させて頂こうと思い購入させて頂きました。丁寧に綺麗に包装 梱包して下さったので 贈り易かったです。又 何かの折りには 購入させて頂こうと思っております。
- toshi8263178
- 家にあった小さなお雛様の置物にぴったりのサイズでした。 両脇にぼんぼりを置いてみると、見栄えが立派になりました。小さなサイズなので、色は朱を選んでみたところ、華やかな雰囲気になりました。
すべて見る
お店の情報
7,367
連絡・応対
4.3
配送スピード
4.3
梱包
4.3